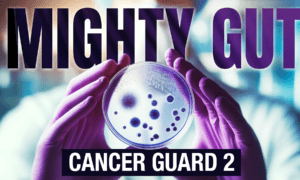
The Epoch Times

Jury Finds Hunter Biden Guilty on All 3 Charges in Gun Trial
Jury Finds Hunter Biden Guilty on All 3 Charges in Gun Trial
Top Stories
Most Read
Backlash Prompts Microsoft to Tighten Security on ‘Recall’ Screenshot Feature
Historical Society Confirms Supreme Court Justices Were Secretly Recorded at Event
Supreme Court Set to Release Rulings on Major Cases as Term Nears End
Sen. Sherrod Brown Aims to Reform Decades-old Social Security Provisions for Public Servants
Judge Cannon Rejects Trump Request in Classified Documents Case
Oklahoma Teacher Shortage Persists for K-12 Public Schools
RFK Jr. Inching Closer to Qualifying for CNN’s June 27 Presidential Debate
Sen. Whitehouse Probes Justice Alito’s Interview With WSJ
COVID-Flu Combination Vaccine Performs Well in Clinical Trial, Moderna Says
US Focused on Strengthening Alliances Near China: Ambassador Burns
Mayorkas Touts ‘Positive’ Early Signs That Biden’s Border Executive Order Is Working
Nevada GOP Primary Candidates Vie for Chance to Unseat Rep. Horsford
Infants Exposed to SARS-CoV-2 During Pregnancy 10 Times More Likely to Have Developmental Delays: Study

An Impassioned Account of Two 19th-Century Political Giants
An Impassioned Account of Two 19th-Century Political Giants
Epoch Readers’ Stories
A History Of The American Nation
Of Cars and Kids
A Nation Divided
What Is Going on Here?
Daylight Saving Time Nonsense
Inspired Stories

Steelers Maintain Stability With Mike Tomlin Extension

Steelers Maintain Stability With Mike Tomlin Extension

Faith-Based Film ‘Forty-Seven Days With Jesus’ Tackles Family Addiction

Faith-Based Film ‘Forty-Seven Days With Jesus’ Tackles Family Addiction

New Risk Assessment Suggest Fewer Americans Would Take Statins: Report

New Risk Assessment Suggest Fewer Americans Would Take Statins: Report

L.M. Montgomery’s Short Story, ‘A Redeeming Sacrifice’

‘Johnny Belinda:’ From Tragedy to Fulfillment

Rufus Dawes and the Iron Brigade

A Disaster, a Single Dad, a Determined Woman, and a Long Time Coming

L.M. Montgomery’s Short Story, ‘A Redeeming Sacrifice’

Home Cellar Part 2: Red Wines

Colorado’s 10 Best Dinosaur Destinations, From Museums to Track Sites and Quarries

For a Lively Vacation, Try Elkhart Lake, Wisconsin

Prohibition Museum Recalls a Turbulent Time in American History
Colorado’s 10 Best Dinosaur Destinations, From Museums to Track Sites and Quarries

Montpelier: The Home of Our Fourth President

The Queen of Hearts: Belle Boyd, Rebel Spy

How the WWII Draft Resulted in a Historic Baseball Moment
The Epoch Times

![[PREMIERING 6/11, 9PM ET] The Transhumanist Age Started With the Contraceptive Pill: Mary Harrington](https://www.theepochtimes.com/_next/image?url=https%3A%2F%2Fimg.theepochtimes.com%2Fassets%2Fuploads%2F2024%2F06%2F11%2Fid5666736-240610-ATL_Mary-Harrington_HD_TN-600x338.jpg&w=1200&q=75)


























































































